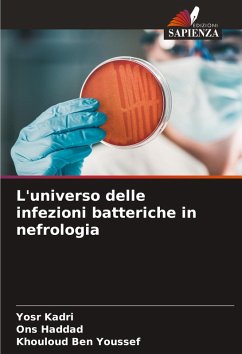

Questa ricerca esplora il complesso mondo delle infezioni batteriche in nefrologia, evidenziando le sfide poste dai batteri multiresistenti. Realizzato presso l'ospedale universitario di Sahloul nell'arco di 9 anni (gennaio 2012 - dicembre 2020), lo studio retrospettivo ha esaminato i ceppi batterici isolati dal reparto di nefrologia. Dei 2851 isolati analizzati, la maggior parte proveniva dall'unità di degenza (83%), seguita dall'unità CPD (9,2%) e dall'unità HD (7,8%). Le infezioni delle vie urinarie sono state le più frequenti nell'unità di degenza (74,6%), con la batteriemia al secondo posto (13%). Questo studio evidenzia l'urgente necessità di comprendere a fondo l'ecologia batterica e la resistenza antimicrobica per ottimizzare la gestione dei pazienti con malattia renale cronica.
Bitte wählen Sie Ihr Anliegen aus.
Rechnungen
Retourenschein anfordern
Bestellstatus
Storno